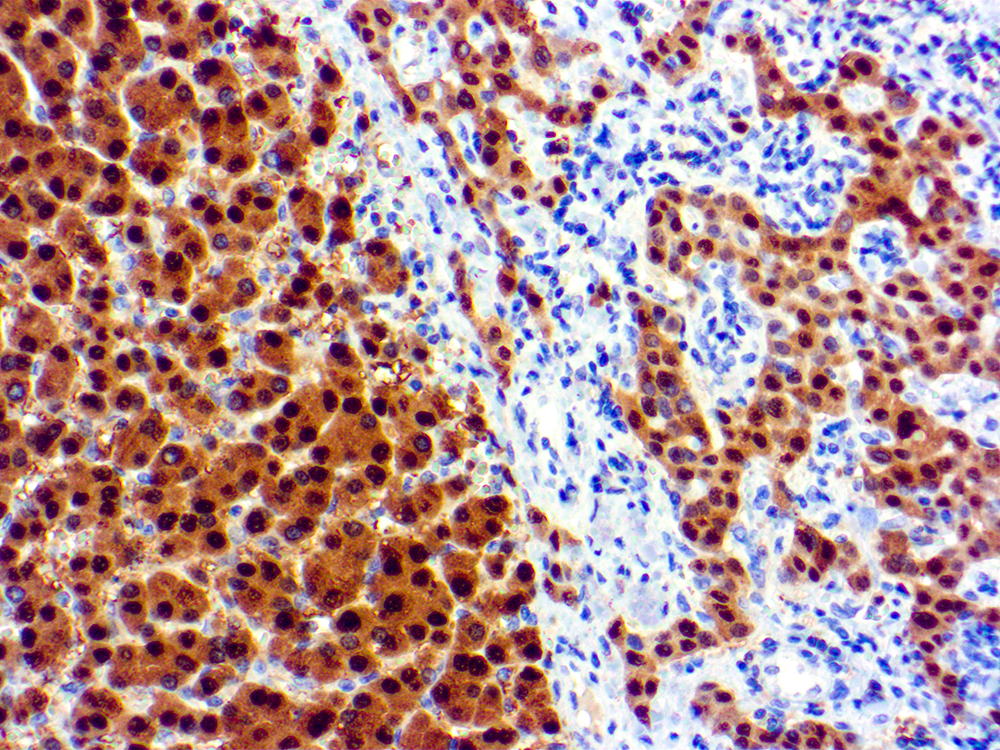

Recognizes a protein of 35-38kDa, which is identified as Arginase 1 (ARG1). Arginase is a manganese metallo-enzyme that catalyzes the hydrolysis of arginine to generate ornithine and urea. Arginase I and II are isoenzymes which differ in subcellular localization, regulation, and possibly function. Arginase I is a cytosolic enzyme, which is expressed mainly in the liver as part of the urea cycle, whereas arginase II is a mitochondrial protein found in a variety of tissues. Antibody to ARG-1 labels hepatocytes in normal tissues and granulocytes in peripheral blood. ARG-1 is a sensitive and specific marker for identification of hepatocellular carcinoma.
Arginase 1
SKU: Mob484-
Categories: Primary Antibodies, IVD - For U.S. Market, IVD - Outside U.S. Market, New Products
Tags: A, Concentrated
Description
Additional information
| Catalog No. | Mob484 Concentrated, PDM197 Prediluted |
|---|---|
| Clone | DBM15.12 |
| Isotype | IgG3, kappa |
| Immunogen | Recombinant fragment (87 Amino acid residues around aa 1- 150) of human ARG1 protein |
| Species | Mouse |
| Cellular Localization | Cytoplasmic |
| Positive Control Tissue | Hepatocellular Carcinoma (HCC) |
| Pretreatment | EDTA Buffer pH 8.0 |
| Incubation & Temperature | 30 min @ RT |
| Intended Use | IVD |
| Detection System | PolyVueTM Plus – Two Step Detection System or Montage PolyVue PlusTM Auto Detection System for Montage 360 System |
| Description/Type | FFPE |
| Format | Purified immunoglobulin |
DATASHEETS & SDS
DATASHEETS & SDS
| Download Datasheet |
| Download SDS Sheet – OSHA |
REFERENCES
REFERENCES
I. Diez, A., et al. 1994. Immunological identity of the two different
molecular mass constitutive subunits of liver arginase. Biol. Chem.
Hoppe Seyler 375: 537-541
Reviews (0)
Only logged in customers who have purchased this product may leave a review.

Reviews
There are no reviews yet.